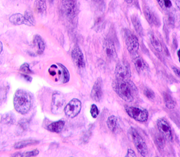
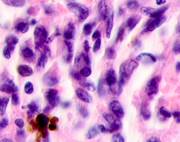
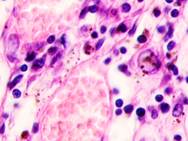
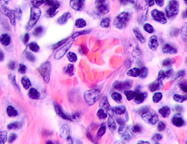
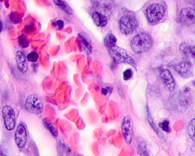

Фото Метастаз Рака Кожи
Фото Метастаз Рака Кожи 114 фотографий
Любовь Новикова Аксенова Горячие Фото
Заварное Печенье Фото
Роналду В Молодости Фото
Картинки Вырезать Склеить И Распечатать Пони
Фото Семьи Шатунова
Панели На Стену Фото
Рога Животных Фото
Деревня Еманжелинка Челябинская Область Фото
Курица На Банке С Картошкой Фото
Картофельные Котлеты Рецепт С Фото